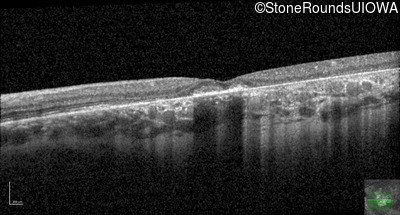

Case
SR2636
Student Mode
AR Stargardt Disease (IIA)
Female
Female
Hidden
SR2636
Student Mode
AR Stargardt Disease (IIA)
Female
Female
History
This 61 year old woman first noticed an abnormality in the center of her vision in dim light when she was 8 years old.
Diagnosis & molecular findings
| Disease | Gene | Allele 1 variant(s) | Allele 2 variant(s) | Inheritance mode |
|---|---|---|---|---|
| AR Stargardt Disease | ABCA4 | Pro1380Leu CCG>CTG | IVS40+5 G>A | AR |
Disease:
Gene:
Allele 1:
Pro1380Leu CCG>CTG
Allele 2:
IVS40+5 G>A
Inheritance:
AR